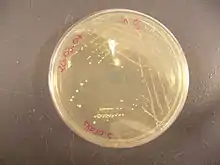

Streptococcus oralis
Streptococcus oralis is a Gram positive bacterium that grows characteristically in chains. It forms small white colonies on a Wilkins-Chalgren agar plate. It is found in high numbers in the oral cavity. It has been classified as a member of the Streptococcus mitis group. Members of this group are opportunistic pathogens. Strains of S. oralis produce neuraminidase and an IgA protease and cannot bind α-amylase.

S. oralis exhibits a carpet‐like arrangement of two or three cell layers on titanium substrates, in vitro.
| Streptococcus oralis | |
|---|---|
![]() | |
| Scientific classification | |
| Domain: | Bacteria |
| Phylum: | |
| Class: | |
| Order: | |
| Family: | |
| Genus: | |
| Species: | S. oralis |
| Binomial name | |
| Streptococcus oralis Bridge and Sneath 1982[1] | |
Natural genetic transformation
S. oralis is competent for natural genetic transformation. Thus S. oralis cells are able to take up exogenous DNA and incorporate exogenous sequence information into their genomes by homologous recombination.[2] These bacteria can employ a predatory fratricidal mechanism for active acquisition of homologous DNA.[2]
References
- Parte, A.C. "Streptococcus". LPSN.
- Johnsborg O, Eldholm V, Bjørnstad ML, Håvarstein LS (2008). "A predatory mechanism dramatically increases the efficiency of lateral gene transfer in Streptococcus pneumoniae and related commensal species". Mol. Microbiol. 69 (1): 245–53. doi:10.1111/j.1365-2958.2008.06288.x. PMID 18485065. S2CID 30923996.
Note
- Marsh, Philip; Michael V. Martin (1999). Oral microbiology. Oxford [England]: Wright. ISBN 978-0-7236-1051-9.
External links
This article is issued from Wikipedia. The text is licensed under Creative Commons - Attribution - Sharealike. Additional terms may apply for the media files.